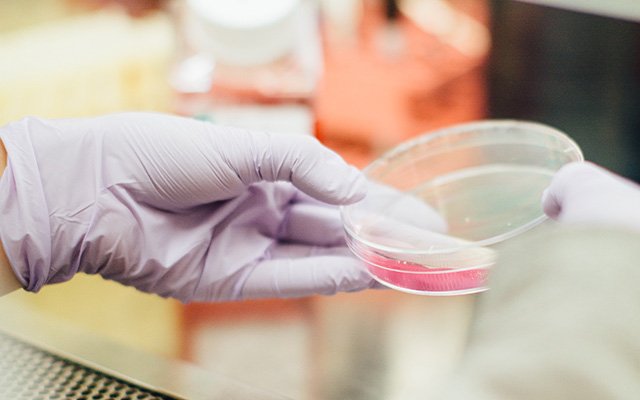

이메일무단수집거부

본 웹사이트에 게시된 이메일 주소가 전자우편 수집 프로그램이나 그 밖의 기술적 장치를 이용하여 무단으로
수집되는 것을 거부하며, 이를 위반 시 정보 통신망법에 의해 형사처벌 됨을 유념하시기 바랍니다.
이메일을 기술적 장치를 사용하여 무단으로 수집, 판매, 유통하거나 이를 이용한 자는 [정보통신망이용촉진 및
정보보호등에 관한 법률] 제 50조의 2조 규정에 의하여 1천만원 이하의 벌금형에 처해집니다.
* 정보통신망법률 제 50조의 2(전자우편주소의 무단 수집행위 등 금지)
1. 누구든지 전자우편주소의 수집을 거부하는 의사가 명시된 인터넷 홈페이지에서 자동으로 전자우편주소를
수집하는 프로그램 그 밖의 기술적 장치를 이용하여 전자우편주소를 수집하여서는 안된다.
2. 누구든지 제1항의 규정을 위반하여 수집된 전자우편주소를 판매·유통하여서는 안된다.
3. 누구든지 제1항 및 제 2항의 규정에 의하여 수집·판매 및 유통이 금지된 전자우편주소임을 알고 이를
정보전송에 이용하여서는 안된다.
작성일 : 2022년 9월 8일


 +
+
 +
+

덴마크 왕립 공과 대학교 대학원 공학박사
덴마크 왕립 공과 대학교 대학원 공학박사
